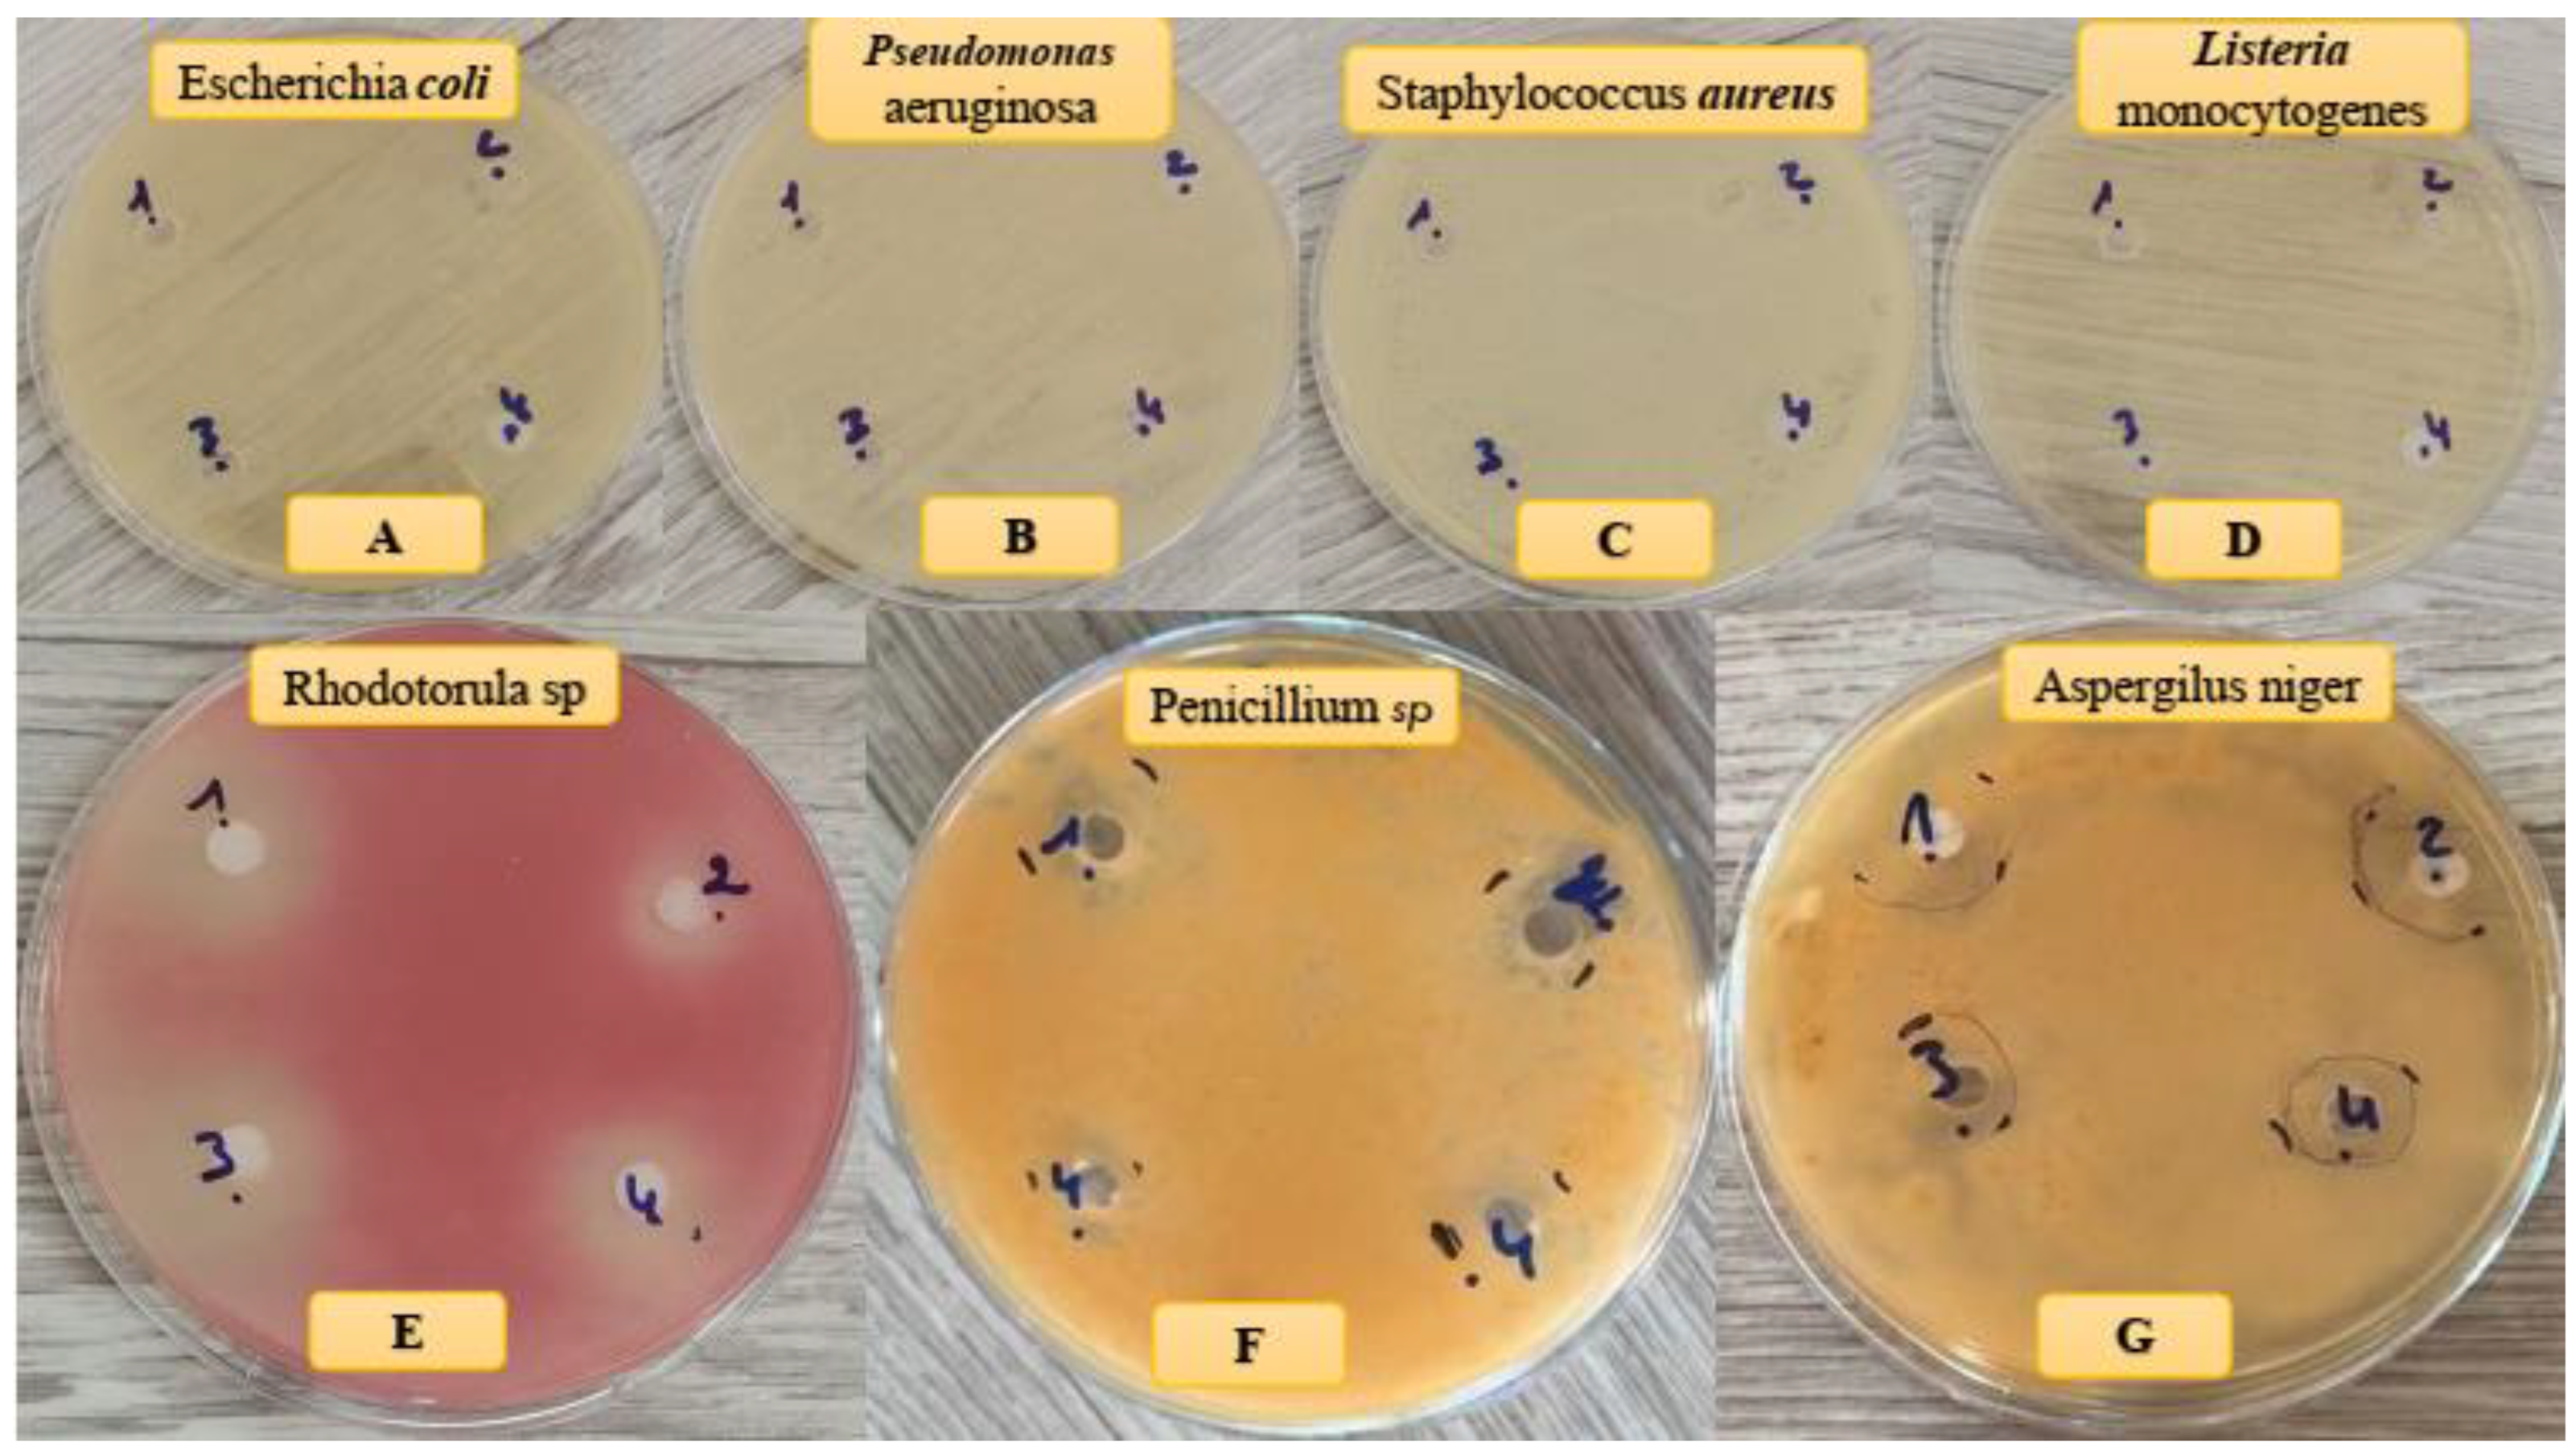
Preprints 92219 g008

1. Introduction
Biocomposites are materials that combine biological and synthetic components to mimic the properties of natural biological materials, such as bones and teeth. These materials have a wide range of biomedical applications, such as tissue engineering, drug delivery, and orthopedic and dental implants [
1,
2]. Biocomposites have several advantages over conventional biomaterials, such as their ability to replicate the mechanical properties of natural biological materials, such as strength and toughness [
3,
4]. Moreover, biocomposites can be designed to be biocompatible, which means that they do not trigger an immune response or cause other adverse reactions in the body[
5,
6]. Furthermore, biocomposites can promote cell growth and differentiation, which can enhance the long-term success of the implant [
7].
One of the most popular types of biocomposites is the chitosan-based composite, which is widely used in tissue engineering and wound healing [
8,
9,
10]. However, another type of biocomposite that has attracted much research interest in recent years is the hydroxyapatite(HAp)-Collagen composite, which is the focus of this paper [
11,
12]. HAp is the main mineral component of human bones and teeth, and it is a calcium phosphate compound with a chemical formula of Ca
10(PO
4)
6(OH)
2 [
13,
14,
15]. HAp-based composites are extensively used in biomedical applications, such as bone repair and regeneration, because of their biocompatibility and osteoconductivity [
15,
16,
17]. Type 1 collagen is the most abundant collagen in the human body, accounting for about 90% of the collagen in our bones [
18]. It is a fibrous protein that provides strength and support to our bones, skin, tendons, and other connective tissues. Type 1 collagen has been studied for its potential use in biomedical applications, such as wound healing and tissue engineering [
19,
20]. HAp-Collagen composites combine the advantages of both HAp and type 1 collagen, offering a biocompatible and osteoconductive material that can mimic the structure and function of natural bone tissue [
11,
21,
22].
Several methods have been developed to synthesize HAp-Collagen composites, and research has focused on various aspects of these composites, such as mechanical properties, biological activity, and degradation [
23,
24]. The synthesis methods for HAp-Collagen composites can be classified into four main categories: sol-gel method, electrospinning method, melt-blending method, and co-precipitation method. Each method has its own advantages and disadvantages, depending on the intended application and desired properties of the final composite. Therefore, the selection of the synthesis method will depend on the specific requirements of the composite and the expected outcomes of the final product.
The sol-gel method involves adding a solution containing calcium and phosphate ions to a collagen solution, resulting in the formation of HAp-Collagen composites [
25]. This method can produce HAp-Collagen composites in various forms, such as thin films, coatings, and hydrogels [
26]. The sol-gel method offers better control over the composition and microstructure of the composite, but it may require high temperatures or pressures for the gelation process. The electrospinning is another method that can produce different forms of HAp-Collagen composites. It involves simultaneously electrospinning a solution containing collagen and a precursor solution containing calcium and phosphate ions to form HAp-Collagen composites in the form of fibers [
27]. This method can produce highly aligned and porous structures that are suitable for tissue engineering applications. However, controlling the electrospinning process can be challenging, unlike the melt-blending method. In the melt-blending method, HAp and collagen powders are melt-blended and then cooled to form HAp-collagen composites in the form of pellets or granules. This method is simple, cost-effective and allows for a high degree of control over the final composition and morphology of the composite. However, it may not be suitable for certain applications, such as tissue engineering, which may require more complex structures, such as scaffolds. The co-precipitation method is a technique that involves mixing calcium and phosphate ions under controlled conditions to form HAp, and then adding collagen to the HAp during the precipitation process, resulting in the formation of HAp-Collagen composites[
28]. This technique can produce HAp-Collagen composites in various forms, such as powders, fibers, and scaffolds. The co-precipitation method is simple and can be performed at room temperature, but it may have some drawbacks, such as the lack of control over the final particle size and shape of the composite, which may affect its mechanical and biological properties [
29].
In this study, we propose a novel co-precipitation method for synthesizing HAp-Collagen composites with potential application as an orthopedic material for bone regeneration. We use HAp nano-powder and type I collagen with varying mass percentages of collagen to HAp. We characterize the composites using several techniques, such as attenuated total reflectance Fourier transform infrared spectroscopy (ATR-FTIR), X-ray diffraction analysis (XRD), thermogravimetric analysis (TGA), scanning electron microscopy (SEM) with energy-dispersive X-ray spectroscopy (EDX), and antimicrobial activity assessment. We compare our results with those obtained from other synthesis methods and discuss the advantages and limitations of our approach. The antimicrobial activity of the nanocomposites is also evaluated in vitro against several bacterial and fungal strains to demonstrate their medical potential. In addition, in silico analyses are performed to predict the absorption, distribution, metabolism, and excretion properties and the bioavailability of the collagen samples.
2. Materials and Methods
2.1. Materials
The reagents used in this study were calcium hydroxide Ca(OH)2 (99%), calcium nitrate tetrahydrate Ca(NO3)2,4H2O (99%), collagen type I (collagen from bovine Achilles tendon) and ammonium hydrogen phosphate (NH4)2HPO4 (99%). They were all purchased from Sigma-Aldrich, Saint-Quentin-Fallavier, France, and were used without further purification.
2.2. Attenuated total reflectance Fourier transform infrared spectroscopy (ATR-FTIR)
ATR-FTIR was used to evaluate the formation of HAp in the composites. The spectra were obtained using a FT/IR-4700 spectrometer (JASCO International LTD., Tokyo, Japan). The spectral range was 400-4000 cm-1, and each spectrum was an average of 32 scans at a resolution of 4 cm-1. A background check was performed before each analysis.
2.3. X-ray diffraction analysis with energy-dispersive X-ray spectroscopy (XRD-EDX)
XRD-EDX was used to investigate the crystal structure and the elemental composition of the composites. The XRD patterns were recorded using a Panalytical X’Pert Pro instrument (Malvern Panalytical GmbH, Kassel, Germany) with a Cu Kα radiation source at 40 kV and 30 mA, and a scan rate of 2°/min. The EDX spectra were obtained using an attached detector on the same instrument.
2.4. Thermogravimetric analysis (TGA)
The composite powder was subjected to standard thermogravimetric analysis using DTG60 instruments (Shimadzu, Germany) to determine its thermal stability. The analysis was conducted in a nitrogen (N2) atmosphere at a heating rate of 10 °C/min from room temperature to 900 °C.
2.5. Scanning electron microscopy (SEM) with energy-dispersive X-ray spectroscopy (EDX)
The SEM images were obtained using a Thermo ScientificTM Quattro ESEM (ThermoFisher Scientific, Paisley, United Kingdom) at an accelerating voltage of 15 kV. The films were sputter-coated with gold before imaging to improve the electron beam conductivity. The EDX spectra were acquired using an attached detector on the same instrument.
2.6. Molecular docking and structure preparation for HAp-Collagen complexes
We obtained the 3D molecular structure of collagen type 1 as a triple-helix region (PDB ID: 7CWK) from the Protein Data Bank, which was determined using X-ray crystallography with a resolution of 1.54 Å. We focused on chain A of collagen, which has a molecular weight of 2.4 kDa, and prepared it for molecular modeling using the PyMol interface. To generate the structure of hydroxyapatite (HAp), we used the HAp unit cell car file, which was available from the INTERFACE-MD software developed by the Heinz group at the University of Colorado at Boulder. The HAp unit cell consists of six PO43- groups, two OH- groups, and ten Ca2+ ions. We designed HAp slabs that contained various numbers of unit cells using the TopoTools v.1.8 VMD plugin. These slabs simulated the Col1, Col2, and Col3 complexes, which correspond to 5, 10, and 30% of the collagen content, respectively. The molecular weights of the slabs were 48, 24, and 8 kDa.
To perform molecular docking, we used the AutoDock and AutoDock Vina (ADVina) programs with default settings and employed genetic and gradient optimization algorithms. We identified the collagen-HAp binding site at the HAp center for each protein-HAp complex. To prepare the structures for molecular docking, we assigned Gasteiger partial charges and defined rotatable bonds according to standard protocols published elsewhere [
30,
31]
2.7. In Silico ADME screening
To estimate the individual ADME (Absorption, Distribution, Metabolism, and Excretion) behaviors of the compounds, the SwissADME software [
32] provided by the Swiss Institute of Bioinformatics [
33] was accessed via a web server. The Submission page of SwissADME available through Google was used for this purpose. Within the software, there is an input zone featuring a molecular sketcher based on Chem Axons Marvin JS [
34]. The structure was then transferred to the right-hand side of the submission page, serving as the input for computation. The list is structured in a way that each line represents an input molecule, with multiple inputs being defined using the simplified molecular input line entry system (SMILES). The results are presented for each molecule in the form of tables, graphs, and an Excel spreadsheet. The SwissADME output file consists of a dedicated panel for each molecule, ensuring a clear output and facilitating export of all molecule-related information [
35].
The following parameters were calculated to determine the physicochemical properties of the synthetized compounds using Open Babel version 2.3.0 [
36,
37]: molecular formula, molecular weight, number of heavy atoms, number of aromatic heavy atoms, fraction, number of rotatable bonds, number of H-bond acceptors, number of H-bond donors, molar refractivity, and topological polar surface area (TPSA). The TPSA method utilizes the summation of tabulated surface contributions of polar fragments, providing a new approach for determining the molecular polar surface area.
2.8. Composite synthesis the dissolution/precipitation method
2.8.1. HAp synthesis
The synthesis method utilized was the dissolution/precipitation of HAp (
Figure 1). This involved dissolving 1 g of HAp powder in 50 ml of distilled water (prepared as described by [
38]), followed by acidification with HNO
3 to break down the apatitic network (dissolution). The pH of the solution was then raised to 9 by adding NH
4OH, which resulted in the re-precipitation of nanometric-sized crystals of HAp.
2.8.2. Composite synthesis
Figure 2 illustrates the synthesis of HAp-collagen composite via the dissolution/precipitation method. Solution A was prepared by dissolving HAp in 50 ml of distilled water and 0.5 ml of HNO
3. On the other hand, Solution B consisted of type I collagen dissolved in 100 ml of 0.5M acetic acid (CH
3COOH), which was stirred for 12 h at 10°C until complete dissolution was achieved.
Solution A was then added dropwise to solution B, while the pH was adjusted to 9 using NH4OH.
The resulting mixture was stirred for 2 h at 25-30°C. To obtain the composite solution, the mixture was filtered, washed with distilled water, and then dried in an oven at 30°C for 6 h. This resulted in the desired composite in the form of a white powder.
Different percentages of HAp and collagen were taken from Solution A and Solution B, as shown in
Table 1.
2.9. Study of the antimicrobial activity
2.9.1. Antibacterial activity
The antibacterial activity of the composites was evaluated in vitro against four bacterial strains: two strains of gram-negative bacteria (
Escherichia coli ATCC 10536 and
Pseudomonas aeruginosa ATCC 49189) and two strains of gram-positive bacteria (
Listeria monocytogenes ATCC 12117 and
Staphylococcus aureus ATCC 6538). These strains were obtained from the laboratory of bioresources, biotechnologies, ethnopharmacology and health (LBBEH), faculty of Sciences, Oujda. The bacteria were maintained in Muller-Hinton broth (MHB; BIOKAR, France) [
39]. A liquid bacterial suspension of 1 ml was added to 9 ml of MHB and incubated at 37°C for 24 h until the microbial suspension reached the exponential growth phase. Bacterial cultures were adjusted to 0.5 McFarland’s standard to achieve a concentration of 1.5×10
8 CFU/ml. The well method was used to evaluate the antibacterial activity. This involved punching the Muller-Hinton agar (MHA) inoculated with the test bacteria (100µL) to create wells, which were then filled with 60 µL of extract. Negative controls were performed using Dimethyl sulfoxide (DMSO), and positive controls using gentamicin. The cultures were incubated for 18 h at 37 °C after a 30-min pre-diffusion at room temperature [
40].The zone of inhibition around the well was measured in mm using a sliding caliper after incubation.
2.9.2.Antifungal activity
The antifungal activity of the composites was evaluated against three strains from the LBBEH. The strains included
Aspergilus niger, Penicillium digitatum and
Rhodotorula glutinis. Petri dishes were prepared by adding 25 ml of sterile Potato Dextrose Agar (PDA) medium for the microorganisms and allowing it to solidify. Then 100 μl of each microorganism (containing 1×10
5 spores) was plated onto the agar dishes and left to dry for 15 min. Wells with a diameter of 6 mm were created on the agar dishes were made using a sterile Pasteur pipette [
41]. The wells were filled with of 60 μL of the extract, while Cycloheximide was used as a positive control and DMSO as a negative control. The dishes were then incubated at 25 °C for 18-48 h. After incubation, the zone of inhibition around each well was measured in mm using a sliding caliper.
3. Results and Discussion
3.1. Chemical composition of composites
The ATR-FTIR spectra show vibrational bands corresponding to OH, NH, CH and PO
43- groups in the synthesized composites (
Figure 3). The band associated with the C-C and C-O bond at approximately 1093.71 cm
-1 overlaps with the PO
43- group. Additionally, contributions from COO
-, C=O, amine (I) and amine (I) groups of collagen, and CO
32- of HAp were observed in the range between 1750 and 1500 cm
-1. The intensity of the bands located between 2800 and 3000 cm
-1 attributed to C-H bonds increases with the percentage of collagen in the composite. Notably, changes after mineralization occur mainly in the range of 500 to 1700 cm
-1. The absorption bands of amides I, II and III were significantly weakened, and the bands of II and III almost disappeared, indicating the formation of a bond between Ca
2+ and R-COO
- of the collagen molecules[
29]. In summary, chemical bonds were formed through the reaction between Ca
2+ on HAp and -COO
- on collagen.
3.2. X-ray diffraction analysis of composites
Figure 4 shows the XRD spectra of HAp-collagen composites (Col 1, Col 2 and Col 3) and HAp (Col 0) synthesized using the co-precipitation method. The XRD spectrum of sample Col 0 indicates that it is poorly crystallized HAp [
42]. The characteristic peaks of HAp (Col 0), including the most intense peak at 2θ = 31.78°, the peak at 2θ =25.70°, and other peaks between 2θ = 40° and 2θ = 55°, are detected. The XRD spectrum of type I collagen (Col 4) exhibited a broad peak in the range of 15°~ 30°, indicating its amorphous structure.
In the composites (Col 1, Col 2 and Col 3), the apatitic structure was preserved despite the increase in the fraction of collagen. However, with an increase in the collagen percentage, the peaks at about 26° and 32° weakened, and the broad peak at about 15° and 30° gradually emerged, suggesting that the components of the composites were adjusted by the preparatory parameters.
3.3. Thermal stability of composites
The significance of temperature in the crystalline transformations and matter transfers during thermal treatment of HAp (Col 0), collagen (Col 4), and composites (Col 1, Col 2, Col 3) can be demonstrated by comparing their respective behaviors. To investigate this, TGA tests were conducted over a temperature range of room to 850 °C.
Figure 5 depicts the thermogravimetric analysis curves for commercial type I collagen, synthetic HAp, and the synthesized composites.
Table 2 presents the remaining and residual masses in percentages for commercial type I collagen, synthesized HAp and the three synthesized composites.
The mass losses presented in
Figure 5 correspond to the removal of water molecules adsorbed on the HAp surface in the first stage, and the release of amino acid chains from collagen in the second stage. At this temperature, collagen can be assumed to detach from the apatite matrix. Among the three composites, there is a noticeable difference in the amount of mass degraded. As shown in
Table 2, the Col 3 composite (20.6946%) undergoes more degradation than the Col 1 (9.0981%) and Col 2 composites (17.8542%).
The Col 1 and Col 2 composites display the smallest amount of mass loss, which can be explained by the respective amounts of HAp in each composite. Thus, the greater the amount of collagen in the material, the greater its mass loss. Furthermore, an increase in the fraction of HAp in the preparatory recipe led to an increase in the fraction of the residue in the products.
3.4. SEM-based morphological study
The scanning electron microscopy was used to study the size, dispersion, and shape of apatite particles on the surface of various synthetic products.
Figure 5 displays the presence of nanoscale particles in composites as agglomerates, with non-uniform particle shapes (
Figure 6). To assess the homogeneity of the HAp-collagen distribution, SEM-EDX mapping was conducted to map the elemental distribution on the surface of sample Col 3 (
Figure 7). This analysis revealed many interesting aspects regarding the distribution of elements.
The signal intensity of each ion is reflected by the intensity of each image. As shown in
Figure 7, Ca, P, N, O and C particles are represented by different colors on the distribution maps. The distribution of composite particles (Col 3) was found to be heterogeneous. The results indicate an increase in the percentage of Carbon (C) and Nitrogen (N) with the percentage increase in collagen. The Ca/P ratio between 1.65 and 1.53 confirmed the formation of non-stoichiometric apatites in all samples.
3.5. Microbial activity
The antimicrobial activity of HAp-collagen composites was evaluated through the sensitivity tests (
Table 3). Our findings indicated that the mass percentage ratios of collagen and HAp significantly influenced the inhibition rate, as shown in
Figure 8 and
Table 3. Specifically, the HAp-collagen composite effectively inhibited the growth of
P. digitatum and
R. glutinis, with an inhibition diameter of approximately 14.3 and 11.0 mm, respectively. Additionally, the composite displayed strong inhibition of
A. niger, with an inhibition diameter of 19.2 mm. Notably, growth inhibition increased with higher collagen percentages. However, we did not observe any antibacterial activity with the HAp-collagen composite (
Figure 8).
Figure 6.
SEM-EDX analysis of composites (Col 0, Col 1, Col 2 and Col 3).
Figure 6.
SEM-EDX analysis of composites (Col 0, Col 1, Col 2 and Col 3).
Figure 7.
EDX mapping of elements O, P, Ca, N and C in the synthesized Col 3 composite.
Figure 7.
EDX mapping of elements O, P, Ca, N and C in the synthesized Col 3 composite.
Table 3.
Inhibition diameter (mm) of composites tested on three fungal and four bacterial strains.
Table 3.
Inhibition diameter (mm) of composites tested on three fungal and four bacterial strains.
| |
Col 0 |
Col 1 |
Col 2 |
Col 3 |
Cycloheximide |
DMSO |
| Penicillium digitatum |
17.1±0.4 |
13.5±0.2 |
11.5±0.2 |
14.3±0.2 |
29.1±0.3 |
00±00 |
| Aspergilus niger |
12.1±0.1 |
15.1±0.2 |
18.03±0.3 |
19.2±0.1 |
22.3±0.02 |
00±00 |
| Rhodotorula glutinis |
13±0.3 |
11.3±0.1 |
10.5±0.2 |
11±0.1 |
28.1±0.1 |
00±00 |
| Escherichia coli |
7.8±0.1 |
8.1±0.3 |
00±00 |
00±00 |
31±0.1 |
00±00 |
| Pseudomonas aeruginosa |
00±00 |
7.2±0.1 |
00±00 |
00±00 |
21±0.2 |
00±00 |
| Staphylococcus aureus |
8±0.2 |
00±00 |
00±00 |
00±00 |
30.7±0.3 |
00±00 |
| Listeria monocytogenes |
00±00 |
00±00 |
00±00 |
00±00 |
30.3±0.2 |
00±00 |
Figure 8.
Antibacterial (A-D) and antifungal (E-G) effects of samples on different bacteria and fungi strains.
Figure 8.
Antibacterial (A-D) and antifungal (E-G) effects of samples on different bacteria and fungi strains.
3.6. Molecular modeling
To investigate the binding between collagen and HAp and its correlation to microbial inhibition, we used different molecular sizes of HAp with collagen percentages of 5, 10, and 30% (
Figure 9). Recent
in silico studies have shed light on the molecular mechanisms underlying this interaction, revealing key binding sites and interactions between collagen and HAp at the atomic level (Almora-Barrios & De Leeuw, 2012; Libonati et al., 2014; Bhowmik et al., 2009). Our computational analyses showed that Col 1 had the lowest AutoDock and ADVina binding energies compared to the other complexes (
Table 1). This observation may be explained by the high stability of the Col 1 composite, as confirmed by TGA experiments, where it showed the lowest percentage of degradation (9.09%) due to the bond formation between Ca
2+ of HAp and -COO
- of collagen. Additionally, Col 1 exhibited the highest microbial inhibition, with an MI
total of 43.01%. It was the only composite that demonstrated a strong antibacterial effect against both
E. coli and
P. aeruginosa.
Furthermore, we calculated the solvent-accessible surface area (SASA) and radius of gyration (Rg) for collagen binding poses obtained from the Col 1, Col 2, and Col 3 complexes, to correlate them with the MI and affinity parameters. Our findings revealed that Col 1 exhibited the highest SASA, which can be attributed to its lowest Gibbs free energy of binding, suggesting a larger intermolecular interface than that of the Col 2 and Col 3 poses (
Table 5). Interestingly, the Rg values for Col 1 and Col 2 were similar, while SASA remained different (
Table 5 and
Figure 10). This discrepancy may be due to changes in the surface conformation or protrusions of the biomolecule without altering its overall size or shape.
Table 4.
Gibbs free energy of binding (ΔGbind) determined by the genetic (AutoDock) and gradient optimization (ADVina) algorithms, inhibition constants (Ki) and total microbial inhibition (MItot) for collagen type 1 bound to HAp.
Table 4.
Gibbs free energy of binding (ΔGbind) determined by the genetic (AutoDock) and gradient optimization (ADVina) algorithms, inhibition constants (Ki) and total microbial inhibition (MItot) for collagen type 1 bound to HAp.
| Complex |
Binding Energy
(Kcal/mol) |
Ki
(µM) |
MItot
(%) |
|
|
| Col 1 |
-45.96 |
-8.2 |
0.98 |
43.01 |
| Col 2 |
-32.74 |
-7.9 |
1.63 |
31.62 |
| Col 3 |
-15.69 |
-5.7 |
66.68 |
34.95 |
Table 5.
Solvent-accessible surface area (SASA) in Å2 and radius of gyration (Rg) in Å calculated for reference (Ref) molecule of collagen type 1 and its binding poses obtained from the Col 1, Col 2, and Col 3 complexes.
Table 5.
Solvent-accessible surface area (SASA) in Å2 and radius of gyration (Rg) in Å calculated for reference (Ref) molecule of collagen type 1 and its binding poses obtained from the Col 1, Col 2, and Col 3 complexes.
| Pose |
SASAavg
|
SASAsum
|
Rg |
| Ref |
1.03 |
367.01 |
21.92 |
| Col 1 |
0.82 |
288.85 |
10.86 |
| Col 2 |
0.76 |
267.77 |
10.97 |
| Col 3 |
0.62 |
218.41 |
8.41 |
3.7. In Silico ADME Predictions
The pharmacological or therapeutic effect of a drug depends on how its physicochemical properties influence the biomolecule that it binds to. In silico approaches are widely used in drug discovery to assess the ADME properties of compounds at the early stages of discovery to identify potential lead molecules. Different physicochemical parameters of drug candidates affect their pharmacokinetic behavior.
Therefore, calculating and measuring these parameters can help prioritize compounds for screening as efficient drug candidates and avoid premature decisions in drug discovery [
22]. A molecule that is likely to be developed as an orally active drug should follow the Lipinski rule of 5 [
23], which states the following four criteria: partition coefficient (Clog P) ≤5, molecular weight (MW) ≤500, number of hydrogen bond acceptors (HBA) ≤10, and number of hydrogen bond donors (HBD) ≤5. Violating more than one of these rules would result in poor bioavailability upon oral administration. According to Veber et al. [
24], the number of rotatable bonds should be ≤10, which is an indicator of good bioavailability. In this study, we calculated several parameters to predict the drug-likeness properties of collagen to screen potential candidate drugs. The molecule was subjected to in silico physicochemical studies such as number of rotatable bonds (nROTB), HBA, HBD, lipophilicity (iLogP), and topological polar surface area (TPSA), which were calculated to understand the drug’s transport properties. The in-silico percentage absorption was calculated using the formula reported by Hou et al. [(%ABS = 109 – (0.345 ×TPSA)] [
25]. The results are shown in
Table 6.
Collagen samples complied with the Lipinski rule of 5, as their molecular weight (MW) ranged from 310 to 410, well below the threshold of 500. Additionally, these collagen samples demonstrated favorable drug-likeness properties, including hydrogen bond acceptors (HBA) ranging from 3 to 7 (≤10), hydrogen bond donors (HBD) in the range of 0–1 (≤5), and iLogP (lipophilicity) ranging between 2.69 and 3.61 (≤5). These characteristics suggest that upon administration, these collagen samples possess properties suitable for drug-like molecules. Furthermore, all collagen samples complied with the Veber rule, with a range of rotatable bonds (nROTB) falling between 5 and 7 (<10), indicating good bioavailability. These findings highlight the potential of collagen samples for absorption and their suitability for therapeutic applications.
Figure 10.
Calculated radius of gyration (Rg) for Ref (A), Col 1 (B), Col 2 (C), and Col 3 (D) conformations of collagen type 1. The Rg parameter is visualized as a sphere with the center corresponding to the center of mass of the molecule. The protein molecule is presented in both cartoon and ball-and-stick representations, colored in green. For clarity purposes, all hydrogen atoms have been omitted from the visualization.
Figure 10.
Calculated radius of gyration (Rg) for Ref (A), Col 1 (B), Col 2 (C), and Col 3 (D) conformations of collagen type 1. The Rg parameter is visualized as a sphere with the center corresponding to the center of mass of the molecule. The protein molecule is presented in both cartoon and ball-and-stick representations, colored in green. For clarity purposes, all hydrogen atoms have been omitted from the visualization.
5. Conclusions
In this study, we developed a new co-precipitation method to synthesize HAp and collagen composites with different ratios of the two components. We carried out detailed characterization of the composites, including their mechanical properties, crystal structure, thermal stability, and antimicrobial activity. We also used in silico methods to predict the absorption, distribution, metabolism, and excretion properties of collagen samples. Consequently, this study presents a comprehensive approach to design, synthesize, and characterize biocompatible HAp- and collagen-based composites, opening new possibilities for biomedical applications, particularly in bone regeneration and orthopedic implantology. Future research directions include studying the biocompatibility and bioactivity of nanocomposites in vivo, as well as exploring other applications and functionalities of these nanocomposites.
Author Contributions
Conceptualization, E.M. and M.A.; methodology, M.A., M.I.Y and M.H.Y.; software, S.S.; validation, B.H., R.S., and K.A.; formal analysis, A.A..; investigation, M.E..; resources, E.M.; data curation, M.A.; writing—original draft preparation, M.A.; writing—review and editing, R.S., K.A., and M.A.; visualization, X.X.; supervision, E.M. and B.H.; project administration, E.M. and M.S.; funding acquisition, M.S. All authors have read and agreed to the published version of the manuscript.
Funding
This research received no external funding.
Institutional Review Board Statement
Not applicable.
Data Availability Statement
The data presented in this study are available upon request from the corresponding author.
Acknowledgments
We thank the heads of the chemistry departments (authors' affiliations) for providing researchers with access to the analytical platform needed for the required analyses.
Conflicts of Interest
The authors declare no conflict of interest.
References
- Kirmanidou, Y.; et al. New Ti-alloys and surface modifications to improve the mechanical properties and the biological response to orthopedic and dental implants: a review. BioMed research international 2016, 2016. [Google Scholar] [CrossRef]
- Memarzadeh, K.; et al. Nanoparticulate zinc oxide as a coating material for orthopedic and dental implants. Journal of Biomedical Materials Research Part A 2015, 103, 981–989. [Google Scholar] [CrossRef] [PubMed]
- Lowenstam, H.A.; Weiner, S. On biomineralization; biomineralization; Oxford University Press on Demand, 1989. [Google Scholar]
- Akartasse, N.; et al. Environmental-friendly adsorbent composite based on hydroxyapatite/hydroxypropyl methyl-cellulose for removal of cationic dyes from an aqueous solution. Polymers 2022, 14, 2147. [Google Scholar] [CrossRef] [PubMed]
- Yang, D.; et al. , The immune reaction and degradation fate of scaffold in cartilage/bone tissue engineering. Materials Science and Engineering: C 2019, 104, 109927. [Google Scholar] [CrossRef] [PubMed]
- Azzaoui, K.; et al. Synthesis and characterization of composite based on cellulose acetate and hydroxyapatite application to the absorption of harmful substances. Carbohydrate polymers 2014, 111, 41–46. [Google Scholar] [CrossRef] [PubMed]
- Ansari, E.G. Etudes de la conception et des différentes propriétés d’un nouveau revêtement bioactif de stents endovasculaires à base de poly (acide [R, S]-3, 3-diméthylmalique)(PDMMLA). Université Paris-Nord-Paris XIII, 2021.
- Lakrat, M.; et al. Synthesis and characterization of composites based on hydroxyapatite nanoparticles and chitosan extracted from shells of the freshwater crab Potamon algeriense. Progress on Chemistry and Application of Chitin and its Derivatives 2020: p. 132-142.
- Madni, A.; et al. Recent advancements in applications of chitosan-based biomaterials for skin tissue engineering. Journal of Bioresources and Bioproducts 2021, 6, 11–25. [Google Scholar] [CrossRef]
- Liu, X.; et al. Chitosan-based biomaterials for tissue repair and regeneration. Chitosan for biomaterials II, 2011: p. 81-127.
- Zhou, Y.; et al. Greener synthesis of electrospun collagen/hydroxyapatite composite fibers with an excellent microstructure for bone tissue engineering. International journal of nanomedicine 2015, 10, 3203. [Google Scholar] [PubMed]
- Sun, R.-X.; et al. Physicochemical and biological properties of bovine-derived porous hydroxyapatite/collagen composite and its hydroxyapatite powders. Ceramics International 2017, 43, 16792–16798. [Google Scholar] [CrossRef]
- Bernache-Assollant, D.; et al. Sintering of calcium phosphate hydroxyapatite Ca10 (PO4) 6 (OH) 2, I. Calcination and particle growth. Journal of the European Ceramic Society 2003, 23, 229–241. [Google Scholar] [CrossRef]
- Wagh, A. Chemically bonded phosphate ceramics: twenty-first century materials with diverse applications; Elsevier, 2016. [Google Scholar]
- Aaddouz, M.; et al. Removal of methylene blue from aqueous solution by adsorption onto hydroxyapatite nanoparticles. Journal of Molecular Structure 2023, 1288, 135807. [Google Scholar] [CrossRef]
- Chen, F.; Zhu, Y.-J. Multifunctional calcium phosphate nanostructured materials and biomedical applications. Current Nanoscience 2014, 10, 465–485. [Google Scholar] [CrossRef]
- Suchanek, W.; Yoshimura, M. Processing and properties of hydroxyapatite-based biomaterials for use as hard tissue replacement implants. Journal of materials research 1998, 13, 94–117. [Google Scholar] [CrossRef]
- Avila Rodríguez, M.I.; Rodríguez Barroso, L.G.; Sánchez, M.L. Collagen: A review on its sources and potential cosmetic applications. Journal of cosmetic dermatology 2018, 17, 20–26. [Google Scholar] [CrossRef]
- Buckley, M. Species identification of bovine, ovine and porcine type 1 collagen; comparing peptide mass fingerprinting and LC-based proteomics methods. International journal of molecular sciences 2016, 17, 445. [Google Scholar] [CrossRef]
- Henriksen, K.; Karsdal, M. Type I collagen, in Biochemistry of collagens, laminins and elastin; Elsevier, 2016; pp. 1–11. [Google Scholar]
- Mallick, M.; Are, R.P.; Babu, A.R. An overview of collagen/bioceramic and synthetic collagen for bone tissue engineering. Materialia 2022, 101391. [Google Scholar] [CrossRef]
- Mushtaq, A.; et al. , Magnetic hydroxyapatite nanocomposites: The advances from synthesis to biomedical applications. Materials & Design 2021, 197, 109269. [Google Scholar]
- Mudhafar, M.; et al. Synthesis and characterization of fish scales of hydroxyapatite/collagen–silver nanoparticles composites for the applications of bone filler. Journal of the Korean Ceramic Society 2021, 1–11. [Google Scholar] [CrossRef]
- Halim, N.A.A.; Hussein, M.Z.; Kandar, M.K. Nanomaterials-upconverted hydroxyapatite for bone tissue engineering and a platform for drug delivery. International journal of nanomedicine 2021, 16, 6477. [Google Scholar] [CrossRef] [PubMed]
- Pelin, I.M.; et al. Preparation and characterization of a hydroxyapatite–collagen composite as component for injectable bone substitute. Materials Science and Engineering: C 2009, 29, 2188–2194. [Google Scholar] [CrossRef]
- Stoch, A.; et al. Sol–gel derived hydroxyapatite coatings on titanium and its alloy Ti6Al4V. Journal of molecular structure 2005, 744, 633–640. [Google Scholar] [CrossRef]
- Teng, S.-H.; et al. Collagen/hydroxyapatite composite nanofibers by electrospinning. Materials Letters 2008, 62, 3055–3058. [Google Scholar] [CrossRef]
- Ficai, A.; et al. , Collagen/hydroxyapatite composite obtained by electric field orientation. Materials Letters 2010, 64, 541–544. [Google Scholar] [CrossRef]
- Chang, M.C.; Tanaka, J. FT-IR study for hydroxyapatite/collagen nanocomposite cross-linked by glutaraldehyde. Biomaterials 2002, 23, 4811–4818. [Google Scholar] [CrossRef] [PubMed]
- Shityakov, S.; Förster, C. ; In silico predictive model to determine vector-mediated transport properties for the blood–brain barrier choline transporter. Advances and Applications in Bioinformatics and Chemistry 2014, 23–36. [Google Scholar] [CrossRef]
- Shityakov, S.; et al. Scaffold Searching of FDA and EMA-Approved Drugs Identifies Lead Candidates for Drug Repurposing in Alzheimer’s Disease. Frontiers in Chemistry 2021, 9, 736509. [Google Scholar] [CrossRef] [PubMed]
- Daina, A.; Michielin, O.; Zoete, V. SwissADME: a free web tool to evaluate pharmacokinetics, drug-likeness and medicinal chemistry friendliness of small molecules. Scientific reports 2017, 7, 42717. [Google Scholar] [CrossRef] [PubMed]
- van Velthoven, M.H.; Cordon, C.; Challagalla, G. Digitization of healthcare organizations: The digital health landscape and information theory. International journal of medical informatics 2019, 124, 49–57. [Google Scholar] [CrossRef]
- Ranjith, D.; Ravikumar, C. SwissADME predictions of pharmacokinetics and drug-likeness properties of small molecules present in Ipomoea mauritiana Jacq. Journal of Pharmacognosy and Phytochemistry 2019, 8, 2063–2073. [Google Scholar]
- Youssoufi, M.H.; et al. POM analyses of antimicrobial activity of 4 H-pyrimido [2, 1-b] benzothiazole, pyrazole, and benzylidene derivatives of curcumin. Medicinal Chemistry Research 2015, 24, 2381–2392. [Google Scholar] [CrossRef]
- Chohan, Z.H.; et al. Design and synthesis of triazole Schiff bases and their oxovanadium (IV) complexes as antimicrobial agents. Journal of Coordination Chemistry 2010, 63, 3981–3998. [Google Scholar] [CrossRef]
- Sheikh, J.; et al. Synthesis, biopharmaceutical characterization, antimicrobial and antioxidant activities of 1-(4′-O-β-d-glucopyranosyloxy-2′-hydroxyphenyl)-3-aryl-propane-1, 3-diones. European journal of medicinal chemistry 2011, 46, 1390–1399. [Google Scholar] [CrossRef] [PubMed]
- Agougui, H.; et al. Synthesis of hydroxyapatite-sodium metasilicate via double decomposition method: Characterization and application to the removal of methylene blue. Inorganic Chemistry Communications 2021, 133, 108986. [Google Scholar] [CrossRef]
- Celiktas, O.Y.; et al. Antimicrobial activities of methanol extracts and essential oils of Rosmarinus officinalis, depending on location and seasonal variations. Food Chemistry 2007, 100, 553–559. [Google Scholar] [CrossRef]
- Pundir, C.S.; Rawal, R. Determination of sulfite with emphasis on biosensing methods: a review. Analytical and bioanalytical chemistry 2013, 405, 3049–3062. [Google Scholar] [CrossRef] [PubMed]
- Pundir, R.K.; Kashyap, S.R. , Kaur, A. Probiotic potential of lactic acid bacteria isolated from food samples: an in vitro study. Journal of Applied Pharmaceutical Science 2013, 3, 085–093. [Google Scholar]
- Maxian, S.H.; Zawadsky, J.P.; Dunn, M.G. In vitro evaluation of amorphous calcium phosphate and poorly crystallized hydroxyapatite coatings on titanium implants. Journal of biomedical materials research 1993, 27, 111–117. [Google Scholar] [CrossRef]
|
Disclaimer/Publisher’s Note: The statements, opinions and data contained in all publications are solely those of the individual author(s) and contributor(s) and not of MDPI and/or the editor(s). MDPI and/or the editor(s) disclaim responsibility for any injury to people or property resulting from any ideas, methods, instructions or products referred to in the content. |
© 2023 by the authors. Licensee MDPI, Basel, Switzerland. This article is an open access article distributed under the terms and conditions of the Creative Commons Attribution (CC BY) license (http://creativecommons.org/licenses/by/4.0/).